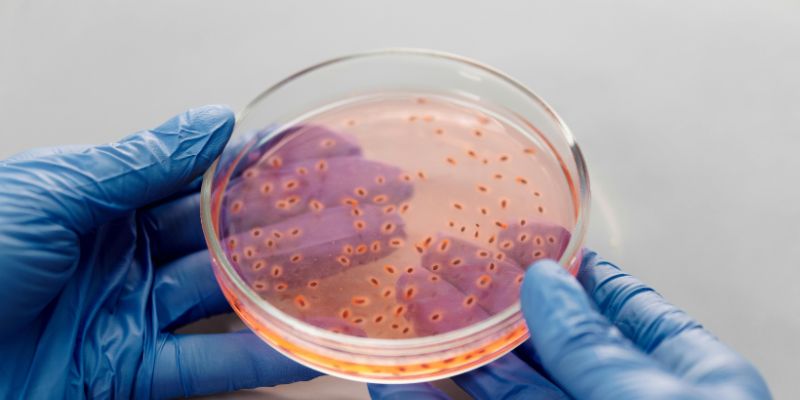
Common Causes of Bacteria in the Urine

Hey there! I’m so glad you’re here to dive into this topic with me. If you’ve ever had a doctor mention “bacteria in the urine” after a test, you might be wondering what it means and whether you should be worried. Trust me, I’ve been there, and I’ve spent a lot of time digging into this subject to understand it better. It can feel a bit overwhelming at first, but I promise it’s not as scary as it sounds.
Let’s break it down together in a way that’s easy to follow, so you can feel confident about what’s going on with your body. Whether you’re dealing with this yourself or just curious, I’ll walk you through what bacteria in the urine means, why it happens, and what you can do about it. Ready? Let’s get started.
Understanding Bacteria in the Urine
So, what does it mean when there’s bacteria in your urine? In simple terms, it means that bacteria, those tiny microorganisms we can’t see without a microscope, have found their way into your urinary tract. Your urinary tract includes your kidneys, bladder, ureters (the tubes that carry urine from the kidneys to the bladder), and urethra (the tube that carries urine out of your body). Normally, urine is sterile, meaning it doesn’t have any bacteria or germs in it. But when bacteria show up in a urine test, it could be a sign of something going on.
I remember the first time I heard about this from my doctor. I was confused and a little nervous. Was it serious? Did I do something wrong? The truth is, finding bacteria in the urine isn’t always a big deal, but it can sometimes point to an infection or other issue. The medical term for bacteria in the urine is “bacteriuria.” It’s pretty common, and it can happen for a lot of different reasons. Let’s explore those reasons next.
Common Causes of Bacteria in the Urine
When I started looking into why bacteria might show up in urine, I was surprised by how many things could cause it. Here are the most common culprits:
- Urinary Tract Infections (UTIs): This is the big one. A UTI happens when bacteria, usually from the skin or digestive system, get into the urinary tract and start multiplying. Most UTIs affect the bladder (called cystitis) or the urethra (urethritis), but they can also reach the kidneys in more serious cases. I’ve had a UTI before, and let me tell you, the burning sensation when you pee is no joke! Women are more likely to get UTIs because their urethra is shorter, making it easier for bacteria to travel up.
- Poor Hygiene Practices: I hate to admit it, but sometimes I’ve rushed through my hygiene routine. Not wiping properly (always front to back, friends!) or not cleaning the genital area well can let bacteria sneak into the urethra.
- Contaminated Samples: This one tripped me up the first time I had a urine test. If the sample isn’t collected properly—like if you don’t clean the area first or you touch the inside of the collection cup—bacteria from your skin can end up in the sample. It’s not always an infection; sometimes it’s just a bad sample.
- Medical Conditions: Some health issues, like diabetes or kidney stones, can make it easier for bacteria to grow in the urinary tract. I learned that high blood sugar can create a cozy environment for bacteria, which is why people with diabetes need to be extra careful.
- Catheters or Medical Procedures: If you’ve ever had a catheter or a procedure involving your urinary tract, bacteria can sometimes hitch a ride. I’ve talked to friends who’ve had catheters, and they said it’s a common risk.
- Asymptomatic Bacteriuria: This one’s interesting. Sometimes, bacteria are present in the urine, but you don’t have any symptoms. It’s more common in older adults or pregnant women. I was surprised to learn that doctors don’t always treat this unless it’s causing problems.
To make this clearer, here’s a quick table summarizing the causes:
| Cause | What It Means |
|---|---|
| Urinary Tract Infection | Bacteria infect the bladder, urethra, or kidneys, causing symptoms like burning. |
| Poor Hygiene | Improper cleaning or wiping can introduce bacteria to the urethra. |
| Contaminated Sample | Bacteria from skin or improper collection can show up in the test. |
| Medical Conditions | Issues like diabetes or kidney stones create conditions for bacterial growth. |
| Catheters/Procedures | Medical devices or procedures can introduce bacteria into the urinary tract. |
| Asymptomatic Bacteriuria | Bacteria are present but don’t cause symptoms; may not need treatment. |
Symptoms to Watch For
Okay, let’s talk about what you might feel if bacteria in your urine is caused by something like a UTI. I’ve been through this, and it’s not fun. Here’s what to look out for:
- Burning or Painful Urination: It feels like fire when you pee. Trust me, you’ll notice this one right away.
- Frequent Urination: You might feel like you need to go every five minutes, even if only a little comes out.
- Cloudy or Smelly Urine: Your urine might look murky or have a strong odor. I once noticed my urine smelled weird and knew something was off.
- Lower Abdominal Pain: A dull ache or pressure in your lower belly can be a sign.
- Blood in Urine: This one freaked me out the first time. If your urine looks pink or red, it could be a sign of infection.
- Fever or Chills: If the infection spreads to your kidneys, you might feel feverish or shivery.
If you don’t have any symptoms but a test shows bacteria, it could be that asymptomatic bacteriuria I mentioned earlier. I learned that it’s usually harmless, but it’s worth talking to your doctor about, especially if you’re pregnant or have other health conditions.
How Doctors Diagnose Bacteria in the Urine
When I first got a urine test result showing bacteria, I was curious about how doctors figure out what’s going on. They usually start with a urinalysis, which is a fancy word for testing your pee. You’ll pee into a cup (make sure to follow the “clean catch” instructions!), and they’ll check it for things like bacteria, white blood cells, or blood.
If the urinalysis shows bacteria, they might do a urine culture. This test grows the bacteria in a lab to figure out exactly what kind it is and which antibiotics will work best. I remember waiting for my culture results and feeling a bit anxious, but it helped my doctor pick the right treatment.
Sometimes, if the infection keeps coming back or seems serious, they might do imaging tests like an ultrasound or CT scan to check your urinary tract for any issues, like blockages or kidney stones. It sounds intense, but it’s just to make sure everything’s okay.
Treatment Options
So, what happens if you have bacteria in your urine? The good news is, most cases are treatable. Here’s what I’ve learned about the options:
- Antibiotics: If you have a UTI, your doctor will likely prescribe antibiotics. I’ve taken them before, and they usually clear things up in a few days. Common ones include nitrofurantoin or amoxicillin. Make sure to finish the whole course, even if you feel better!
- Increased Fluid Intake: Drinking lots of water helps flush out bacteria. I started chugging water when I had a UTI, and it really helped ease the symptoms.
- Pain Relief: Over-the-counter meds like phenazopyridine can help with the burning sensation. I found it was a lifesaver while waiting for antibiotics to kick in.
- No Treatment (Sometimes): If you have asymptomatic bacteriuria and you’re not pregnant or having surgery, your doctor might just keep an eye on it. I was surprised to learn that not every case needs antibiotics.
- Addressing Underlying Issues: If something like kidney stones or diabetes is causing the problem, your doctor will work on treating that too.
One thing I’ve learned is to always follow your doctor’s advice. Don’t skip doses or stop antibiotics early—it can make things worse.
Prevention Tips I Swear By
After dealing with a UTI, I got serious about preventing bacteria in my urine. Here are some tips that have worked for me:
- Drink Plenty of Water: Staying hydrated keeps your urinary tract flushed out. I aim for at least eight glasses a day.
- Practice Good Hygiene: Always wipe front to back, and clean the genital area daily. It’s a small habit that makes a big difference.
- Pee After Sex: This one was a game-changer for me. Urinating after intercourse helps flush out any bacteria that might have gotten into the urethra.
- Avoid Irritants: Things like scented soaps or douches can irritate your urethra and make infections more likely. I stick to gentle, fragrance-free products now.
- Wear Loose Clothing: Tight pants can trap moisture and bacteria. I switched to breathable cotton underwear, and it’s been great.
- Cranberry Products: There’s some evidence that cranberry juice or supplements can help prevent UTIs. I drink cranberry juice occasionally, but check with your doctor first.
When to See a Doctor
I can’t stress this enough: if you have symptoms like burning, frequent urination, or blood in your urine, don’t wait. I made the mistake of ignoring my symptoms once, and the infection got worse. Call your doctor right away if you notice anything unusual. If you have a fever, back pain, or feel really sick, it could be a kidney infection, which needs immediate attention.
Even if you don’t have symptoms but a test shows bacteria, talk to your doctor. They’ll help you figure out if it’s something to watch or treat, especially if you’re pregnant, have diabetes, or are older.
My Personal Experience
I’ll be honest—dealing with bacteria in my urine was a wake-up call for me. The first time I had a UTI, I didn’t know what was happening. The burning, the constant trips to the bathroom—it was miserable. But after working with my doctor, drinking more water, and being more mindful about hygiene, I’ve managed to keep it under control. I’ve also learned to listen to my body. If something feels off, I don’t ignore it anymore. Sharing this with you feels like passing on what I wish I’d known sooner.

Conclusion
So, there you have it—everything I’ve learned about what bacteria in the urine means. It’s not something to panic about, but it’s definitely worth paying attention to. Whether it’s a simple UTI, a contaminated sample, or something else, understanding the causes, symptoms, and treatments can make all the difference. I hope this has helped clear things up for you, just like it did for me when I was figuring it all out.
By staying hydrated, practicing good hygiene, and listening to your body, you can keep your urinary tract happy and healthy. If you’re ever in doubt, your doctor is your best friend. Thanks for sticking with me through this—here’s to feeling your best!
FAQs
What causes bacteria to show up in a urine test?
Bacteria in a urine test can come from a urinary tract infection, poor hygiene, a contaminated sample, or medical conditions like diabetes. Sometimes, it’s asymptomatic bacteriuria, where bacteria are present but don’t cause symptoms. Always check with your doctor to understand the cause.
Is bacteria in the urine dangerous?
It depends. A UTI can be uncomfortable and needs treatment, but it’s usually not dangerous if treated promptly. Asymptomatic bacteriuria might not need treatment unless you’re pregnant or have other risk factors. Kidney infections are more serious, so see a doctor if you have fever or severe pain.
How can I prevent bacteria in my urine?
Drink plenty of water, wipe front to back, pee after sex, and avoid irritating products like scented soaps. Wearing loose, breathable clothing and considering cranberry products can also help. Good hygiene is key!
Can I treat bacteria in the urine at home?
You can support your body by drinking water and taking over-the-counter pain relief for symptoms, but you’ll likely need antibiotics for a UTI. Always see a doctor for proper diagnosis and treatment. Don’t try to treat it on your own.
Why do women get UTIs more often?
Women have a shorter urethra, so bacteria can travel to the bladder more easily. Hormonal changes, pregnancy, and sexual activity can also increase the risk. That’s why hygiene and prevention tips are so important for us.
